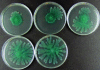

Cell-cell signaling in Xanthomonas campestris involves an HD-GYP domain protein that functions in cyclic di-GMP turnover
- PMID: 16611728
- PMCID: PMC1458946
- DOI: 10.1073/pnas.0600345103
Cell-cell signaling in Xanthomonas campestris involves an HD-GYP domain protein that functions in cyclic di-GMP turnover
Retraction in
-
Retraction for Ryan et al., Cell-cell signaling in Xanthomonas campestris involves an HD-GYP domain protein that functions in cyclic di-GMP turnover.Proc Natl Acad Sci U S A. 2017 Aug 15;114(33):E7031. doi: 10.1073/pnas.1712524114. Epub 2017 Aug 7. Proc Natl Acad Sci U S A. 2017. PMID: 28784774 Free PMC article. No abstract available.
Abstract
HD-GYP is a protein domain of unknown biochemical function implicated in bacterial signaling and regulation. In the plant pathogen Xanthomonas campestris pv. campestris, the synthesis of virulence factors and dispersal of biofilms are positively controlled by a two-component signal transduction system comprising the HD-GYP domain regulatory protein RpfG and cognate sensor RpfC and by cell-cell signaling mediated by the diffusible signal molecule DSF (diffusible signal factor). The RpfG/RpfC two-component system has been implicated in DSF perception and signal transduction. Here we show that the role of RpfG is to degrade the unusual nucleotide cyclic di-GMP, an activity associated with the HD-GYP domain. Mutation of the conserved H and D residues of the isolated HD-GYP domain resulted in loss of both the enzymatic activity against cyclic di-GMP and the regulatory activity in virulence factor synthesis. Two other protein domains, GGDEF and EAL, are already implicated in the synthesis and degradation respectively of cyclic di-GMP. As with GGDEF and EAL domains, the HD-GYP domain is widely distributed in free-living bacteria and occurs in plant and animal pathogens, as well as beneficial symbionts and organisms associated with a range of environmental niches. Identification of the role of the HD-GYP domain thus increases our understanding of a signaling network whose importance to the lifestyle of diverse bacteria is now emerging.
Conflict of interest statement
Conflict of interest statement: No conflicts declared.
Figures

References
-
- Cámara M., Williams P. A., Hardman A. Lancet Infect. Dis. 2002;2:667–676. - PubMed
-
- Ross P., Weinhouse H., Aloni Y., Michaeli D., Weinberger-Ohana P., Mayer R., Braun S., de Vroom E., van der Marel G. A., van Boom J. H., et al. Nature. 1987;325:279–281. - PubMed
-
- Galperin M. Y., Nikolskaya A. N., Koonin E. V. FEMS Microbiol. Lett. 2001;203:11–21. - PubMed
-
- Römling U., Gomelsky M., Galperin M. Y. Mol. Microbiol. 2005;57:629–639. - PubMed
Publication types
MeSH terms
Substances
Grants and funding
LinkOut - more resources
Full Text Sources
Other Literature Sources
Research Materials

